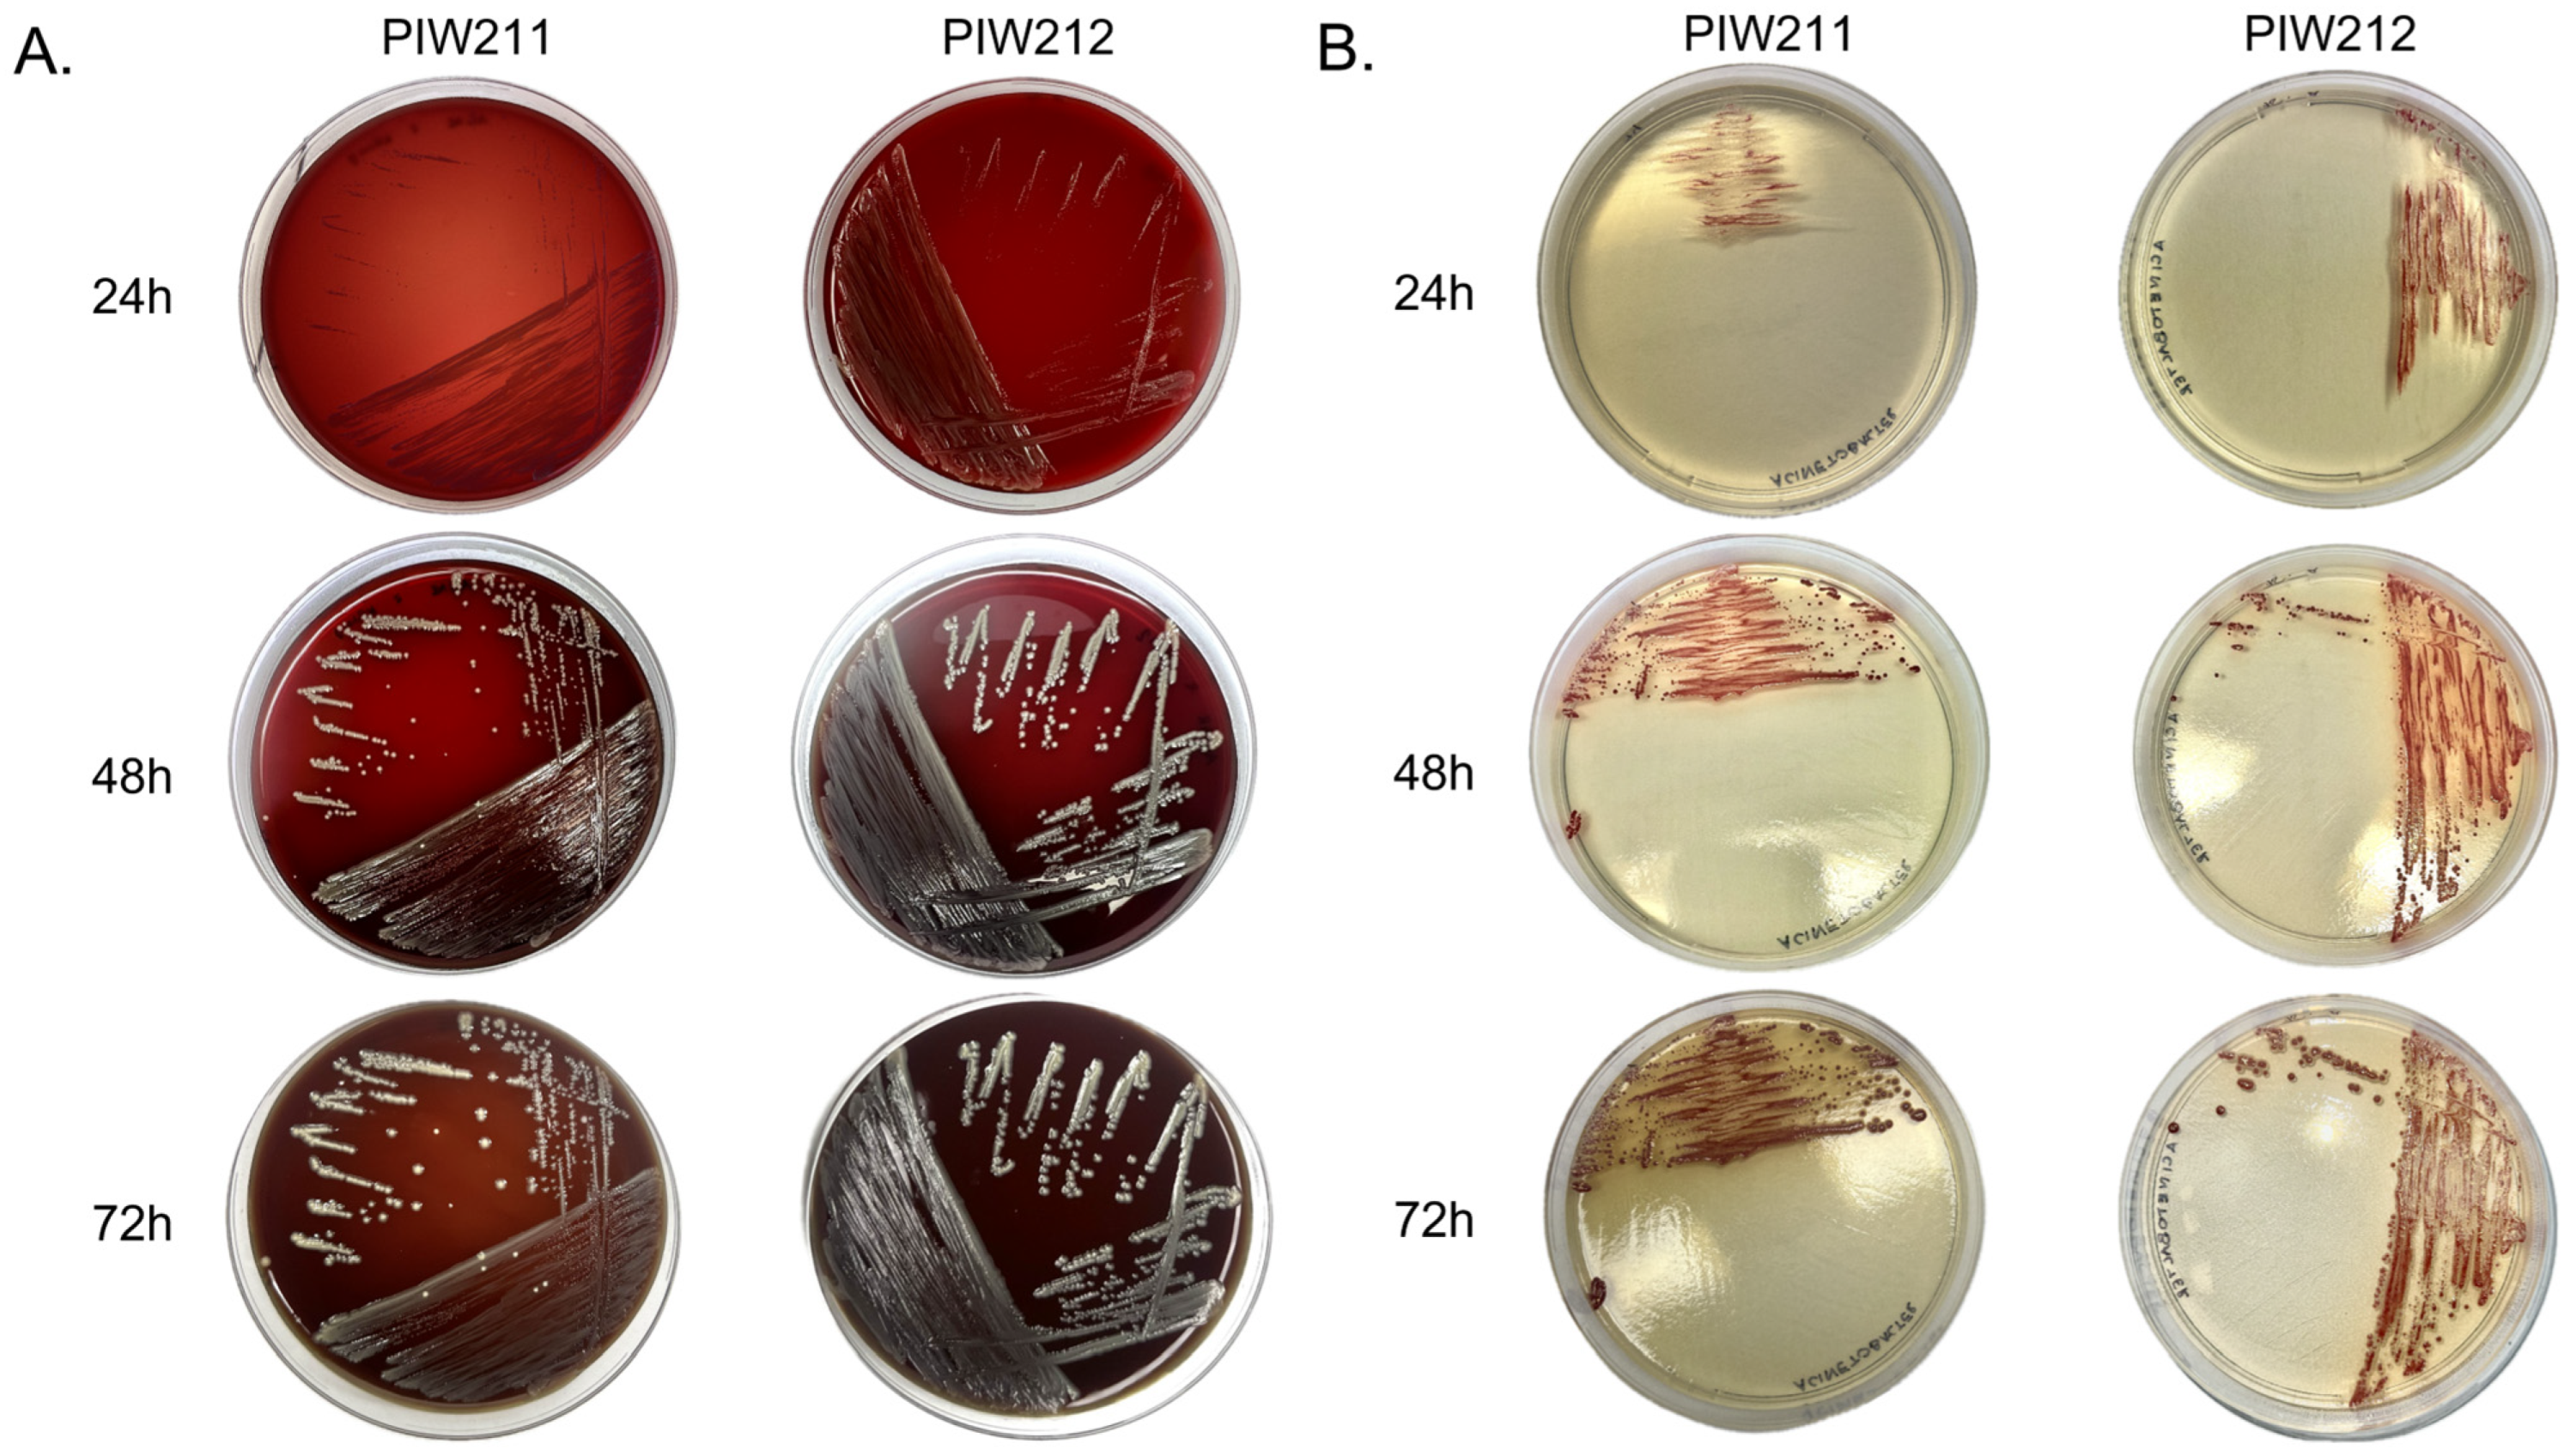

Detection and Whole-Genome Characteristics of Bordetella trematum Isolated from Captive Snakes
Abstract
1. Introduction
2. Materials and Methods
2.1. Bacteria Isolation and Identification
2.2. Whole-Genome Sequencing and Bioinformatic Analysis
3. Results
3.1. Bacteria Identification and Antimicrobial Resistance Typing
3.2. The Genome Analysis
3.3. Phylogenetic Analysis
4. Discussion
4.1. Isolation, Identification, and Potential Reservoirs of Bordetella trematum
4.2. Antimicrobial Resistance of Bordetella trematum
4.3. Invasiveness of Bordetella
5. Conclusions
Supplementary Materials
Author Contributions
Funding
Institutional Review Board Statement
Informed Consent Statement
Data Availability Statement
Acknowledgments
Conflicts of Interest
References
- Vandamme, P.; Heyndrickx, M.; Vancanneyt, M.; Hoste, B.; De Vos, P.; Falsen, E.; Kersters, K.; Hinz, K.H. Bordetella trematum sp. nov., isolated from wounds and ear infections in humans, and reassessment of Alcaligenes denitrificans Rüger and Tan 1983. Int. J. Syst. Bacteriol. 1996, 46, 849–858. [Google Scholar] [CrossRef] [PubMed]
- Castro, T.R.; Martins, R.C.R.; Dal Forno, N.L.F.; Santana, L.; Rossi, F.; Schwarzbold, A.V.; Costa, S.F.; Trindade, P.A. Bordetella trematum infection: Case report and review of previous cases. BMC Infect. Dis. 2019, 19, 485. [Google Scholar] [CrossRef] [PubMed]
- Saksena, R.; Manchanda, V.; Mittal, M. Bordetella trematum bacteremia in an infant: A cause to look for. Indian J. Med. Microbiol. 2015, 33, 305–307. [Google Scholar] [CrossRef]
- Daxboeck, F.; Goerzer, E.; Apfalter, P.; Nehr, M.; Krause, R. Isolation of Bordetella trematum from a diabetic leg ulcer. Diabet. Med. 2004, 21, 1247–1248. [Google Scholar] [CrossRef]
- Hamidou Soumana, I.; Linz, B.; Harvill, E.T. Environmental Origin of the Genus Bordetella. Front. Microbiol. 2017, 8, 28. [Google Scholar] [CrossRef]
- Kersters, K.; Hinz, K.H.; Hertle, A.; Segers, P.; Lievens, A.; Siegmann, O.; DeE Ley, J. Bordetella avium sp. nov., isolated from the respiratory tracts of turkeys and other birds. Int. J. Syst. Bacteriol. 1984, 34, 56–70. [Google Scholar] [CrossRef]
- von Wintzingerode, A.F.; Schattke, R.A.; Siddiqui, U.; Rösick, U.; Göbel, U.B.; Gross, R. Bordetella petrii sp. nov., isolated from an anaerobic bioreactor, and emended description of the genus Bordetella. Int. J. Syst. Evol. Microbiol. 2001, 51 Pt 4, 1257–1265. [Google Scholar] [CrossRef] [PubMed]
- Tazato, N.; Handa, Y.; Nishijima, M.; Kigawa, R.; Sano, C.; Sugiyama, J. Novel environmental species isolated from the plaster wall surface of mural paintings in the Takamatsuzuka tumulus: Bordetella muralis sp. nov., Bordetella tumulicola sp. nov. and Bordetella tumbae sp. nov. Int. J. Syst. Evol. Microbiol. 2015, 65, 4830–4838. [Google Scholar] [CrossRef]
- Buechler, C.; Neidhöfer, C.; Hornung, T.; Neuenhoff, M.; Parčina, M. Detection and Characterization of Clinical Bordetella trematum Isolates from Chronic Wounds. Pathogens 2021, 10, 966. [Google Scholar] [CrossRef]
- Shah, D.H.; Board, M.M.; Crespo, R.; Guard, J.; Paul, N.C.; Faux, C. The occurrence of Salmonella, extended-spectrum β-lactamase producing Escherichia coli and carbapenem-resistant non-fermenting Gram-negative bacteria in a backyard poultry flock environment. Zoonoses Public Health 2020, 67, 742–753. [Google Scholar] [CrossRef]
- Guo, G.; Di, Z.; Yang, N.; Li, X.; Zeng, J.; Zheng, J. Rare environmental and endogenous bacteria isolated from a captive Chinese cobra (Naja atra) with acute enteritis in Hainan, China. Res. Sq. 2023. [Google Scholar] [CrossRef]
- Lin, W.H.; Tsai, T.S. Comparisons of the Oral Microbiota from Seven Species of Wild Venomous Snakes in Taiwan Using the High-Throughput Amplicon Sequencing of the Full-Length 16S rRNA Gene. Biology 2023, 12, 1206. [Google Scholar] [CrossRef] [PubMed]
- Annex to Commission Implementing Decision (UE) 2020/1729. Available online: https://www.legislation.gov.uk/eudn/2020/1729/body (accessed on 20 June 2024).
- Shifu, C. Ultrafast one-pass FASTQ data preprocessing, quality control, and deduplication using fastp. iMeta 2023, 2, e107. [Google Scholar] [CrossRef]
- Kaas, R.S.; Leekitcharoenphon, P.; Aarestrup, F.M.; Lund, O. Solving the problem of comparing whole bacterial genomes across different sequencing platforms. PLoS ONE 2014, 9, e104984. [Google Scholar] [CrossRef]
- Letunic, I.; Bork, P. Interactive Tree of Life (iTOL) v6: Recent updates to the phylogenetic tree display and annotation tool. Nucleic Acids Res. 2024, 52, W78–W82. [Google Scholar] [CrossRef] [PubMed]
- Grant, J.R.; Enns, E.; Marinier, E.; Mandal, A.; Herman, E.K.; Chen, C.; Graham, M.; Van Domselaar, G.; Stothard, P. Proksee: In-depth characterization and visualization of bacterial genomes. Nucleic Acids Res. 2023, 51, W484–W492. [Google Scholar] [CrossRef]
- Seemann, T. Prokka: Rapid prokaryotic genome annotation. Bioinformatics 2014, 30, 2068–2069. [Google Scholar] [CrossRef] [PubMed]
- Bortolaia, V.; Kaas, R.S.; Ruppe, E.; Roberts, M.C.; Schwarz, S.; Cattoir, V.; Philippon, A.; Allesoe, R.L.; Rebelo, A.R.; Florensa, A.R.; et al. ResFinder 4.0 for predictions of phenotypes from genotypes. J. Antimicrob. Chemother. 2020, 75, 3491–3500. [Google Scholar] [CrossRef]
- Alcock, B.P.; Huynh, W.; Chalil, R.; Smith, K.W.; Raphenya, A.R.; Wlodarski, M.; Edalatmand, A.; Petkau, A.; Syed, S.A.; Tsang, K.K.; et al. CARD 2023: Expanded curation, support for machine learning, and resistome prediction at the Comprehensive Antibiotic Resistance Database. Nucleic Acids Res. 2023, 51, D690–D699. [Google Scholar] [CrossRef]
- Almuzara, M.; Barberis, C.; Traglia, G.M.; Sly, G.; Procopio, A.; Vilches, V.; Ramírez, M.S.; Famiglietti, A.M.; Vay, C.A. Isolation of Bordetella species from unusual infection sites. JMM Case Rep. 2015, 2, e000029. [Google Scholar] [CrossRef]
- Kukla, R.; Svarc, M.; Bolehovska, R.; Ryskova, L.; Paterova, P.; Fajfr, M.; Malisova, L.; Zemlickova, H. Isolation of Bordetella trematum from the respiratory tract of a patient with lung cancer: A case report. Folia Microbiol. 2020, 65, 623–627. [Google Scholar] [CrossRef] [PubMed]
- Wong, C.; Calungsud, L.G.; La, M.V. Bordetella trematum bacteraemia secondary to an empyema in an immunocompromised host: A case report and review of the literature. Access Microbiol. 2023, 13, acmi000602.v3. [Google Scholar] [CrossRef] [PubMed]
- Wirsing von Koning, C.H.; Riffelmann, M.; Coenye, T. Bordetella and related genera. In Manual of Clinical Microbiology; Versalovic, J., Carroll, K.C., Funke, G., Jorgensen, J.H., Landry, M.L., Warnock, D.W., Eds.; ASM Press: Washington, DC, USA, 2011; pp. 739–750. [Google Scholar] [CrossRef]
- Bonilla-Aldana, D.K.; Bonilla-Aldana, J.L.; Ulloque-Badaracco, J.R.; Al-Kassab-Córdova, A.; Hernandez-Bustamante, E.A.; Alarcon-Braga, E.A.; Siddiq, A.; Benites-Zapata, V.A.; Rodriguez-Morales, A.J.; Luna, C.; et al. Snakebite-Associated Infections: A Systematic Review and Meta-Analysis. Am. J. Trop. Med. Hyg. 2024, 110, 874–886. [Google Scholar] [CrossRef]
- Hu, S.; Lou, Z.; Shen, Y.; Tu, M. Bacteriological Studies of Venomous Snakebite Wounds in Hangzhou, Southeast China. Am. J. Trop. Med. Hyg. 2022, 107, 925–929. [Google Scholar] [CrossRef]
- Public Health England (PHE); National Health Service (NHS). UK Standards for Microbiology Investigations: Identification of Bordetella Species; ID-5; National Health Service (NHS): London, UK, 2020; pp. 1–18.
- Almagro-Molto, M.; Eder, W.; Schubert, S. Bordetella trematum in chronic ulcers: Report on two cases and review of the literature. Infection 2015, 43, 489–494. [Google Scholar] [CrossRef] [PubMed]
- Adesoji, A.T.; Ogunjobi, A.A. Detection of extended spectrum beta-lactamases resistance genes among bacteria isolated from selected drinking water distribution channels in southwestern Nigeria. BioMed Res. Int. 2016, 2016, 7149295. [Google Scholar] [CrossRef]
- Kadlec, K.; Schwarz, S. Antimicrobial Resistance in Bordetella bronchiseptica. Microbiol. Spectr. 2018, 6, 1–11. [Google Scholar] [CrossRef] [PubMed]
- Beier, D.; Gross, R. The BvgS/BvgA phosphorelay system of pathogenic Bordetellae: Structure, function and evolution. Adv. Exp. Med. Biol. 2008, 631, 149–160. [Google Scholar] [CrossRef]
- Linz, B.; Ivanov, Y.V.; Preston, A.; Brinkac, L.; Parkhill, J.; Kim, M.; Harris, S.R.; Goodfield, L.L.; Fry, N.K.; Gorringe, A.R.; et al. Acquisition and loss of virulence-associated factors during genome evolution and speciation in three clades of Bordetella species. BMC Genom. 2016, 30, 767. [Google Scholar] [CrossRef] [PubMed]
- Uhl, M.A.; Miller, J.F. Central Role of the BvgS Receiver as a Phosphorylated Intermediate in a Complex Two-component Phosphorelay. J. Biol. Chem. 1996, 271, 33176–33180. [Google Scholar] [CrossRef]

| Antimicrobial | PIW211 | Interpretation | PIW212 | Interpretation |
|---|---|---|---|---|
| Amikacin | 8 | NA | 8 | NA |
| Ampicillin | 2 | S | 2 | S |
| Azithromycin | ≤2 | NA | ≤2 | NA |
| Cefotaxime | >4 | R | >4 | R |
| Ceftazidime | 8 | R | 4 | S |
| Chloramphenicol | ≤8 | NA | ≤8 | NA |
| Ciprofloxacin | 1 | R | 1 | R |
| Colistin | ≤1 | NA | ≤1 | NA |
| Gentamicin | 2 | NA | 4 | NA |
| Meropenem | ≤0.03 | S | ≤0.03 | S |
| Nalidixic Acid | 8 | NA | 8 | NA |
| Sulphamethoxazole | ≤8 | NA | ≤8 | NA |
| Tetracycline | ≤2 | S | ≤2 | S |
| Tigecycline | ≤0.25 | NA | ≤0.25 | NA |
| Trimethoprim | 16 | R | 16 | R |
Disclaimer/Publisher’s Note: The statements, opinions and data contained in all publications are solely those of the individual author(s) and contributor(s) and not of MDPI and/or the editor(s). MDPI and/or the editor(s) disclaim responsibility for any injury to people or property resulting from any ideas, methods, instructions or products referred to in the content. |
© 2025 by the authors. Licensee MDPI, Basel, Switzerland. This article is an open access article distributed under the terms and conditions of the Creative Commons Attribution (CC BY) license (https://creativecommons.org/licenses/by/4.0/).
Share and Cite
Zając, M.; Bona, I.; Skarżyńska, M.; Kwit, R.; Lalak, A.; Skrzypiec, E.; Mikos-Wojewoda, E.; Pasim, P.; Wojdat, D.; Koza, W.; et al. Detection and Whole-Genome Characteristics of Bordetella trematum Isolated from Captive Snakes. Pathogens 2025, 14, 49. https://doi.org/10.3390/pathogens14010049
Zając M, Bona I, Skarżyńska M, Kwit R, Lalak A, Skrzypiec E, Mikos-Wojewoda E, Pasim P, Wojdat D, Koza W, et al. Detection and Whole-Genome Characteristics of Bordetella trematum Isolated from Captive Snakes. Pathogens. 2025; 14(1):49. https://doi.org/10.3390/pathogens14010049
Chicago/Turabian StyleZając, Magdalena, Inga Bona, Magdalena Skarżyńska, Renata Kwit, Anna Lalak, Ewelina Skrzypiec, Emilia Mikos-Wojewoda, Paulina Pasim, Dominika Wojdat, Weronika Koza, and et al. 2025. "Detection and Whole-Genome Characteristics of Bordetella trematum Isolated from Captive Snakes" Pathogens 14, no. 1: 49. https://doi.org/10.3390/pathogens14010049
APA StyleZając, M., Bona, I., Skarżyńska, M., Kwit, R., Lalak, A., Skrzypiec, E., Mikos-Wojewoda, E., Pasim, P., Wojdat, D., Koza, W., & Wasyl, D. (2025). Detection and Whole-Genome Characteristics of Bordetella trematum Isolated from Captive Snakes. Pathogens, 14(1), 49. https://doi.org/10.3390/pathogens14010049

